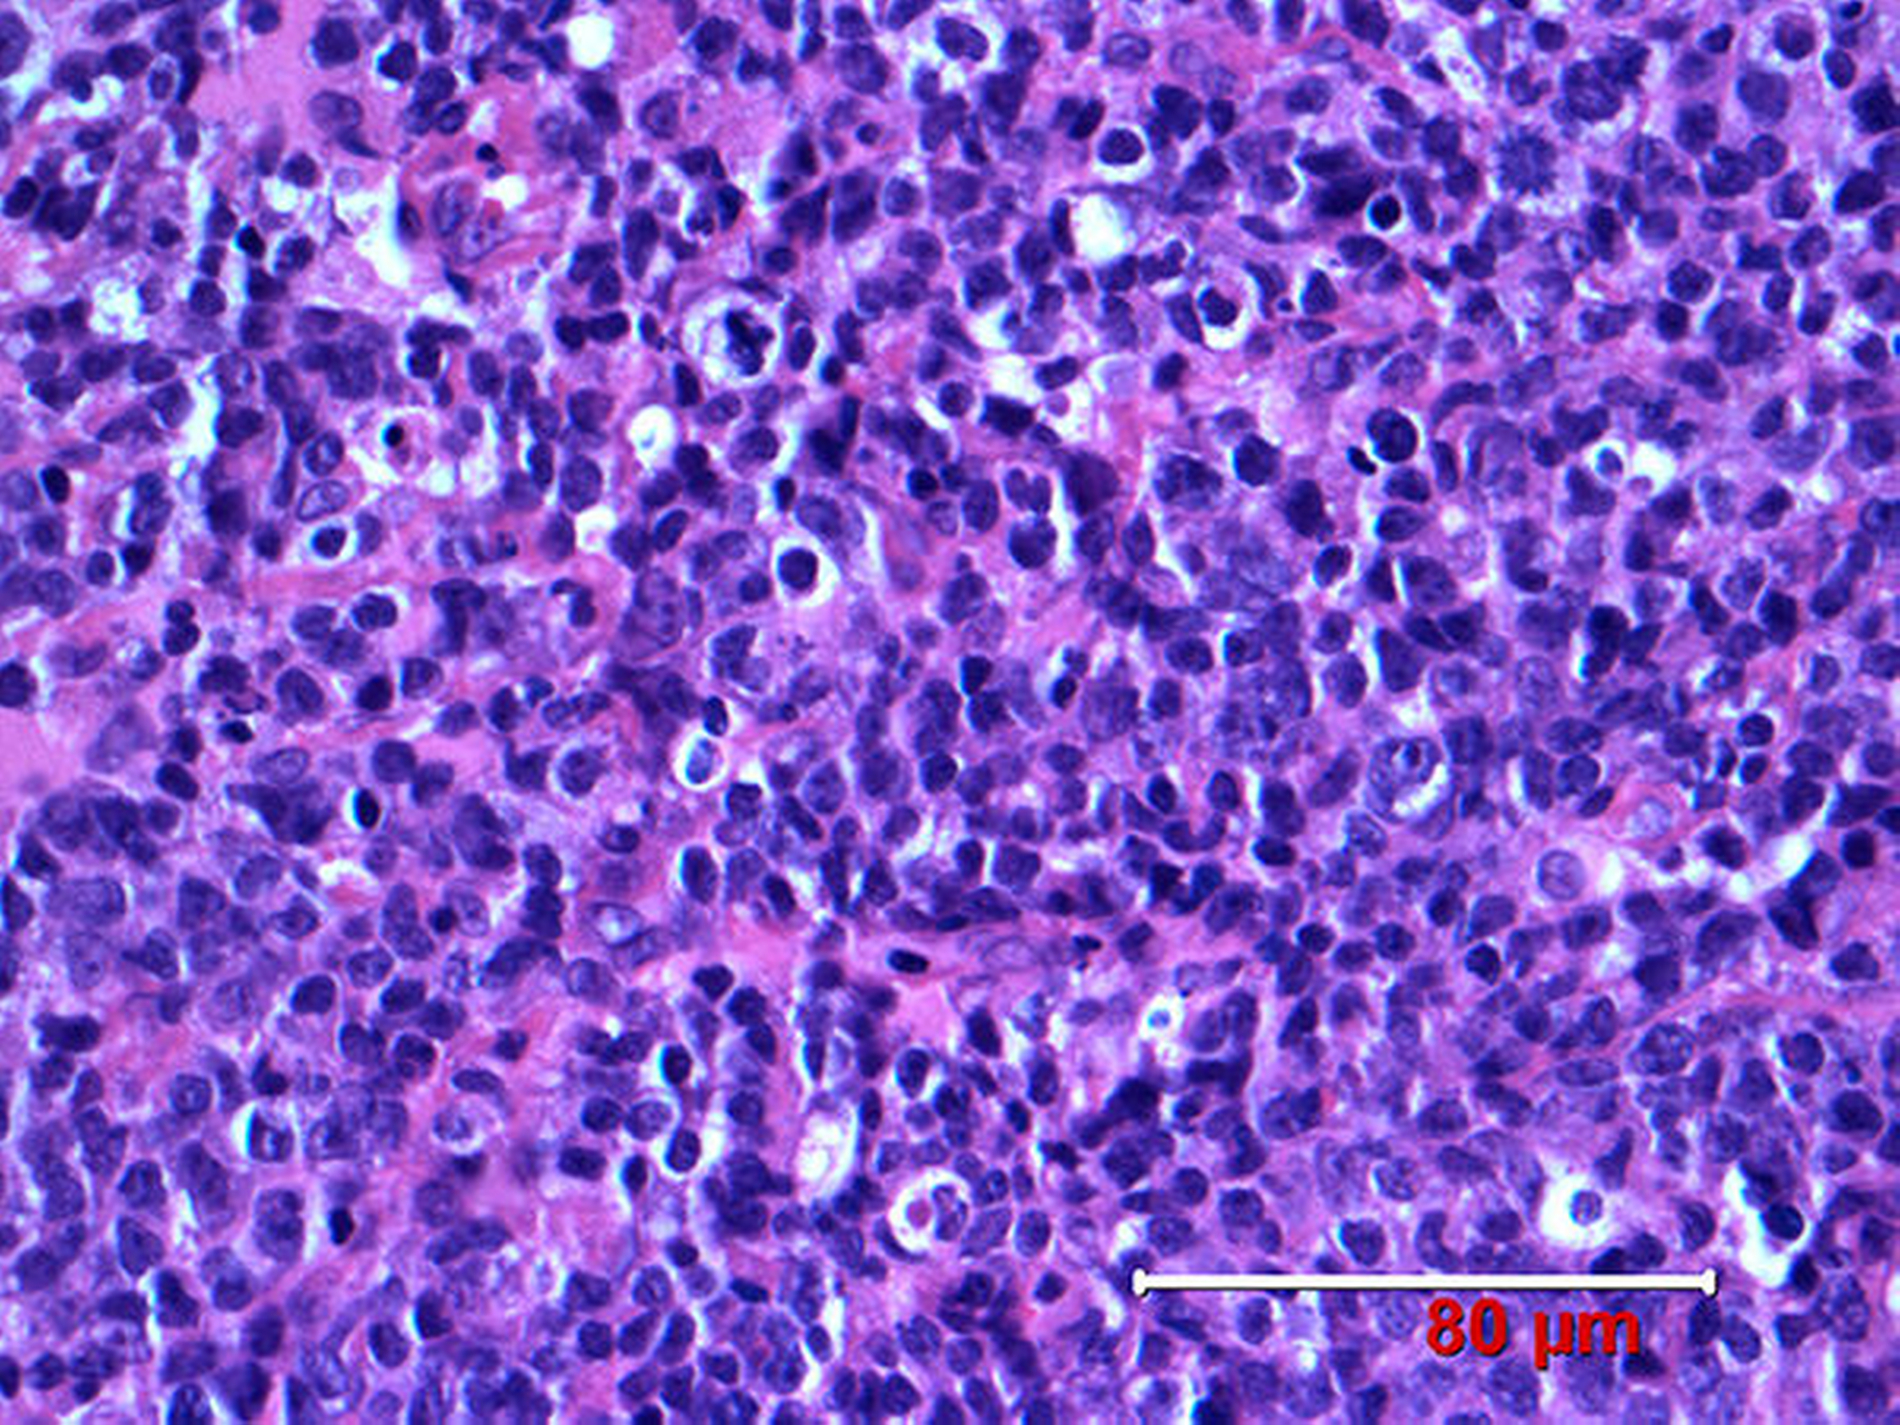

Simultane Manifestation eines Non-Hodgkin-Lymphoms
Ein 70-jähriger türkischer Patient wurde nach primärer zahnärztlicher Konsultation auf Überweisung eines niedergelassenen Mund-, Kiefer-, Gesichtschirurgen mit Verdacht auf ein Plattenepithelkarzinom des Oberkiefers und cervicalen Metastasen in unserer allgemeinen Ambulanz vorstellig.
Anamnese
Der Patient gibt eine persistierende Schwellung im Halsbereich seit vier Wochen an. Des Weiteren berichtete er, dass die Prothese im Oberkiefer seit mehreren Wochen nicht mehr passen würde. Daraufhin habe er seinen Zahnarzt konsultiert, worauf die Überweisung zum niedergelassenen Chirurgen erfolgte. Eine histologische Sicherung wurde in der Praxis nicht durchgeführt.
Der Patient gab keine Schmerzen an. Auf Nachfrage erzählte er jedoch, dass er in den letzten Wochen 5 kg abgenommen habe, zudem bestand eine Nachtschweiß-Symptomatik. Die allgemeine Anamnese war ansonsten unauffällig, der Patient gab keine Erkrankungen, Allergien oder Medikamenteneinnahme an. Daneben bestand ein Nikotinabusus mit etwa 20 Zigaretten pro Tag seit 57 Jahren, Alkohol wurde verneint.
Diagnostik
Bei der extraoralen Untersuchung fand sich eine ausgedehnte raumfordernde Schwellung cervical rechts bis nach supraklavikulär und nuchal reichend (Abbildung 1a). Diese war derb, nicht verschieblich, nicht druckdolent und nicht fluktuierend und zeigte sich auch in der Sonografie malignomsuspekt (Abbildung 1b).
Die Haut war verschieblich und zeigte keine Rötung. Der extraorale Neurostatus war unauffällig. Intraoral fand sich eine ausgedehnte Raumforderung (3,5cm x 3cm) im Bereich des Oberkiefers und palatinal mit Mittellinienüberschreitung (Abbildung 2).
Die Oberfläche war leicht erosiv und zeigte zudem ulceröse Anteile, welche auf Berührung bluteten. Der Oberkiefer war zahnlos, eine Prothese wurde nicht mehr getragen. Im Unterkiefer fand sich ein Teleskop an Zahn 43 als Restbezahnung mit Teleskopprothese in situ. Ein mitgebrachtes Fremd-OPG zeigte keine pathologischen Veränderungen, Osteolysen fanden sich nicht.
Bei hochgradigem Verdacht auf ein Malignom wurde der Patient daraufhin stationär zum Staging aufgenommen. In der Labordiagnostik fanden sich unauffällige Routine-Parameter in der klinischen Chemie, dem Blutbild, der Gerinnung und Serologie (Hepatitis B und C sowie HIV), lediglich die Blutkörper-Senkung war mit 45 mm/Std erhöht (Referenz <20 mm/Std). In der durchgeführten Kopf-Hals-CT fand sich eine tumoröse Raumforderung des Oberkiefers und Gaumens mit einer Größe von 37mm x 22mm mit Mittellinienüberschreitung und Einbeziehung des Alveolarkamms (Abbildung 3a).
Der Knochen war arrodiert. Daneben zeigten sich ausgedehnte pathologische Raumforderungen cervical rechts vom Unterkieferrand bis nach supraklavikulär reichend unter Einbeziehung der Nervgefäßscheide (Abbildung 3b) bei unauffälligem cranialem CT.
Im CT-Thorax wurden vermehrte, nicht vergrößerte Lymphknoten prätracheal sowie beidseits hilär beschrieben. In der Abdomen-Sonografie fand sich ein echoreicher Leberherd mit einem Durchmesser von 1,5cm im Sinne eines Hämangioms. Die Pan-Endoskopie war bis auf die oben beschriebenen Befunde unauffällig.
Therapie
Es erfolgte daraufhin eine operative Revision mit Probeentnahme cervical über einen extraoralen Zugang sowie eine Biopsie von intraoral mit Tumorinspektion. Die pathohistologische Begutachtung ergab ein hochmalignes Non-Hodgkin-Lymphom der B-Zell-Reihe, entsprechend einem diffusen großzelligen B-Zell-Lymphom der WHO-Klassifikation (Abbildung 4).
Der klinische Verlauf zeigte keine Komplikationen, im nachgezogenen Differenzialblutbild fanden sich keine Veränderungen. Der Patient wurde daraufhin zur Therapie-Übernahme in der Universitätsklinik für Hämatologie und internistische Onkologie Essen vorgestellt. Dort wurde eine Immun-Polychemotherapie nach dem R-CHOP-Protokoll (Rituximab, Cyclophosphamid, Doxorubicin, Vincristin, Prednison) unter Kontrolle des Ansprechens durch FDG-PET-Untersuchungen (PETAL-Studie) eingeleitet. Unter der Chemotherapie zeigte sich eine deutliche Rückbildung. Bei der letztmaligen Vorstellung des Patienten zwei Jahre nach Erstdiagnose befand sich der Patient in kompletter Remission ohne Beschwerdesymptomatik im Mund-, Kiefer-, Gesichtsbereich.
Diskussion
Als malignes Lymphom bezeichnet man bösartige Tumore des lymphatischen Systems, welche also von den lymphatischen Zellen (T- und B-Zellen) oder Organen (Lymphknoten, Tonsillen, Thymus, Milz) ausgehen. Wie bei anderen malignen Erkrankungen vermehren sich die Lymphzellen enthemmt und ohne Wachstumskontrolle.
Als mögliche Ursachen werden verschiedene immunsupprimierende Mechanismen wie chemische Substanzen / medikamentöse Therapien, Strahlen, onkologische Viren, Immundefizienzen (wie AIDS), Autoimmunerkrankungen als auch genetische Veranlagungen diskutiert [Harris et. al., 2001].
Das maligne Lymphom macht etwa 4 bis 5 Prozent der Krebserkrankungen aus [Parkin et. al., 2001]. Die Inzidenz liegt bei etwa 10 bis 15 / 100.000 Einwohner, so dass circa 15.000 neue Erkrankungen pro Jahr in Deutschland mit einem Erkrankungsgipfel im sechsten Lebensjahrzehnt auftreten. Lymphome im Kindesalter (wie lymphoblastisches Lymphom) sind selten [Wollner et. al., 1992].
Innerhalb der malignen Lymphome werden histologisch zwei große Gruppen unterschieden: das Hodgkin-Lymphom, auch Morbus Hodgkin genannt, und das Non-Hodgkin-Lymphom. Beide können sich über das lymphatische System ausbreiten, extralymphatische Organe sind meist aber im Rahmen von Non-Hodgkin-Lymphomen durch Tumorinfiltration des benachbarten Gewebes oder durch hämatogene Streuung betroffen. So weisen 30 Prozent der Non-Hodgkin-Lymphome eine primär extranodale Manifestation auf [Hashimoto et. al., 1982]. In fünf Prozent der Non-Hodgkin-Lymphome sind die Kiefer mitbetroffen [Adler, 1983]. Weitere häufige Lokalisationen im Kopf-Hals-Bereich sind die Orbita, Haut, Speicheldrüsen und Mundhöhle [Baum et. al., 2016]. Non-Hodgkin-Lymphome gehen zu etwa 90 Prozent von B-Zellen und circa 10 Prozent von T-Zellen aus Lob et. al., 1991].
Die Einteilung der malignen Lymphome basiert auf der WHO-Klassifikation [Dürkop et. al., 2011], welche einen internationalen Konsensus und somit einheitliche Klassifizierung erreichte. Die Stadien-Einteilung erfolgt nach dem 1971 auf einer Konferenz in Ann Arbour (USA) entwickelten System in vier Gruppen anhand der systemischen Ausbreitung [Lister et. al., 1989] (Tabelle).
Die klinische Symptomatik ist meist unspezifisch. In der Regel findet sich ein indolenter raumfordernder Prozess oder eine Lymphknotenschwellung, wie auch im vorliegenden Fall, Müdigkeit, Fieber, Nachtschweiß, Gewichtsverlust sowie Infektanfälligkeit. Daneben treten vor allem organ- beziehungsweise lokalisationsspezifische Symptome (wie Exophthalmus) auf [Steg et. al., 1959].
Diagnostisch kommen neben der Anamnese und der klinischen Untersuchung auch Laboruntersuchungen (Differenzial-Blutbild, klinische Chemie), bildgebende Verfahren (CT / MRT / Sonografie / Szintigrafie / konventionelle Röntgenaufnahmen) und Knochenmarkbiopsien zum Einsatz [Gallamini et. al., 2016]. Daneben kann die Diagnose durch eine Biopsie sichergestellt werden, und sollte daher immer erfolgen. Je nach Lokalisation können noch weitere diagnostische Untersuchungen, wie zum Beispiel eine augenärztliche Untersuchung, notwendig werden.
Therapeutisch stehen mit der Chemotherapie, Strahlentherapie, Stammzelltransplantation und Antikörpertherapie individuelle, multimodale Konzepte zur Verfügung, welche eine interdisziplinäre Zusammenarbeit nach hämato-onkologischer Vorstellung notwendig machen [Nishioka et. al., 2004]. Eine chirurgische Therapie im Sinne einer Sanierung kommt nur in Einzelfällen zum Einsatz und sollte in enger Kooperation mit den Onkologen besprochen werden.
In der vorliegenden Kasuistik handelt es sich um ein diffuses großzelliges B-Zell Lymphom, welches den aggressiven Lymphomen (intermediate risk) zugeordnet wird [Staudt et. al., 2005].
Interessant erscheint hier die Tatsache, dass es zu einem simultanen Befall des Oberkiefers und der Halsregion gekommen ist, so dass aufgrund der intraoralen Symptomatik und morphologischen Veränderung zunächst der Verdacht auf ein Plattenepithelkarzinom alio loco gestellt wurde.
Trotz der ausgedehnten Raumforderung cervical war es die nicht mehr passende Prothese im Oberkiefer, weswegen der Patient den Zahnarzt aufsuchte. Von daher zeigt sich exemplarisch, dass der Zahnarzt bei intraoralen Raumforderungen durch die Untersuchung und das Erkennen eines pathologischen Prozesses die Weichen für die weitere Therapie stellt.
Daneben erscheint interessant, dass sich im Rahmen der Diagnostik, insbesondere der Sonografie, der cervicale Befund eher untypisch für eine vorliegende Metastasierung eines intraoralen Malignoms darstellte, so dass diesbezüglich die Indikation zur intra- und extraoralen Biopsie gestellt wurde.
Bei Verdacht auf ein Plattenepithelkarzinom mit Metastasierung wäre sicherlich auf die extraorale Biopsie verzichtet worden. In dieser Hinsicht sollte die Diagnostik vor der Biopsie vollständig sein. Bei Verdacht auf ein Lymphom sollte daher eine Überweisung des Patienten zum Staging, zur Diagnosesicherung und Planung des weiteren Procederes in ein tertiäres Zentrum erfolgen.
Fazit für die Praxis
Der Zahnarzt ist meistens erster Ansprechpartner bei intraoralen Raumforderungen und stellt somit die Weichen für die weitere Diagnostik und Therapie.
Intraorale Lymphome sind selten, sollten aber bei der Differenzialdiagnose bedacht werden.
Die Symptomatik ist meist unspezifisch.
Die Diagnostik und Therapie sollte in einem tertiären Zentrum erfolgen.
Dr. Dr. Sven Holger Baum
Prof. Dr. Dr. Christopher Mohr
Universitätsklinik für Mund-, Kiefer- und Gesichtschirurgie Essen
Kliniken Essen-Mitte
Henricistr. 92, 45136 Essen
s.baum@kliniken-essen-mitte.de